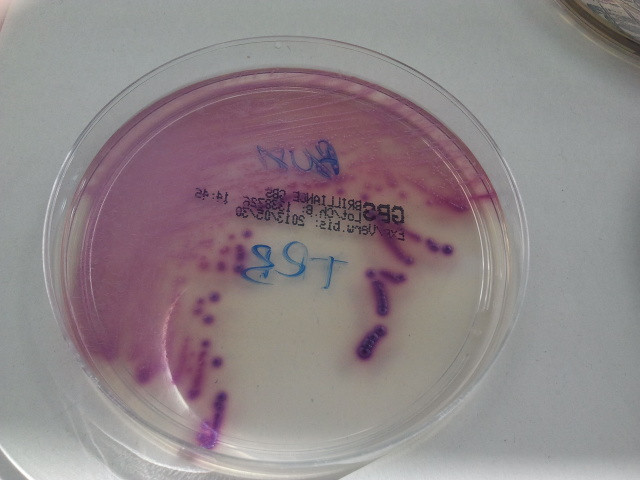

Codice insegnamento 67405
Ricevimento Anna Marchese: qualsiasi giorno della settimana previa richiesta di appuntamento via posta elettronica all'indirizzo: anna.marchese@unige.it
Inizio lezioni: Si rimanda all’ Agenda Web | Università degli Studi di Genova, reperibile al seguente link
https://easyacademy.unige.it/portalestudenti/
Corsi di laurea, sedi, programma, obiettivi, modalità d'esame e altre informazioni
Modulo, vedi anche: MALATTIE INFETTIVE E MICROBIOLOGIA CLINICA - 67402
- Docente: Anna Marchese